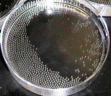
シャーレで受精

希少魚の調査研究
希少種の調査研究
環境研究部 自然環境グループ (生物多様性センター)
希少種の保全において最も大切なことは,自然の生息地を守り,野生の個体群が健全に生存し続けることです。また,それと平行して,万が一,野生個体が絶滅した場合にも種を絶やさないために,人為管理下で種を保存することも必要となります。当センターでは府内に生息している希少淡水魚の保全に関する研究を行なっています。
イタセンパラ
生物多様性センターでは所内のイタセンパラ保存池で累代飼育を行うとともに,生息地での環境調査,人工繁殖や精子の凍結保存の技術開発を行ってきました。
Ⅰ 生態
10月,山の木々が色づき始める頃、イタセンパラのオスは鮮明な紫色の婚姻色を身にまといます。一方,メスは産卵管という卵を産むための特別な管を伸ばし,生きているイシガイ科の二枚貝の中に卵を産みこみます。一週間ほどでふ化した仔魚は,貝の中で冬を越し,翌春の5月頃に貝から泳ぎ出ます。
貝から出たばかりの仔魚は,ミジンコなどの動物性プランクトンを食べていますが,成長とともに次第に植物性へと食性が変化し,付着藻類や水底の堆積物などをつつくように食べます。
採集したイタセンパラを一時的にバケツなどに収容すると,短時間で多量の糞が排泄され,か細い姿に似合わず,非常に大食漢です。寿命は1~2年程で,成長しても全長8から12cmほどです。春に貝から泳ぎ出た仔魚は,その年の秋には卵を産めるようになります。
産卵行動 -どうやって貝に卵を産み込むの?-
Ⅱ 効率的な自然繁殖 -産み込み易い貝はどの貝?-
イシガイ科の二枚貝7種類を使って,オスが好んでなわばりを張り,メスが卵を産みこみやすい貝の種類を調べました。その結果,イシガイ,ササノハガイ,小型のドブガイをイタセンパラはよく利用することが分かりました。
Ⅲ 人工繁殖
1. 貝の代わりにシャーレで育てる
イタセンパラをたくさん増やすためには,卵を託す二枚貝が必要です。しかし,二枚貝は太陽の光を受けて育つ植物プランクトンを餌にしているため,水槽の中では長生きしません。
そこで,安定的かつ計画的にイタセンパラを増やすために,貝を使わずに増殖させる方法を検討しました。そこで,卵からふ化した仔魚が育つために必要な温度条件などを詳しく調べた結果,シャーレの中でイタセンパラの仔魚を育てることに成功しました。
シャーレの中で育ったイタセンパラの卵と仔魚
●一定温度で発育できないイタセンパラ
動物の胚は、一般的に環境の変化に弱く、温度が大きく変わると、発育が悪くなったり、死んでしまう場合があります。そこでまず、イタセンパラの胚に温度変化を与えないようにし5、10、15、20、25、30℃の各一定温度で発育させてみました。しかし、どの温度で発育させても、順調に育たず、自ら泳ぎ出す仔魚はいませんでした。
●発育には、大きな温度変化が必須
そこで、各発育段階に必要な温度条件を調べてみました。すると、受精から孵化が15~25℃、低温要求期が5℃、発眼(目に色がつく段階)が10~15℃、浮上(自ら泳ぐ段階)が20~30℃となり、発育に伴って大きな温度変化が必要なことがわかりました。
●日本の気候に進化適応
イタセンパラの発育に必要な温度条件は、実際の生息地の温度とどのように対応しているのでしょうか。そこで、イタセンパラが自然繁殖している池の水温を計り、実験で求めた温度条件と比較してみました。その結果、発育に伴って必要とする温度は、自然環境の温度変化ときれいに対応していることがわかりました。 なんと、イタセンパラは自らの発育条件を、日本の気候に合わせ進化適応させているようです。このように特異なイタセンパラの発生学的特徴は、魚類で初めての発見となりました。
●保全に向けて
発育に合わせて、必要な温度域(受精から孵化:15~25℃、低温要求期:5℃、発眼:10~15℃、浮上:20~30℃)を適切に変化させると、受精卵の約70%が正常に育ち、泳ぎ出しました。イタセンパラの未知の生態が解明されたことによって、人工繁殖が容易になり、安定した種の保存が可能となりました。
Ⅳ 精子の凍結保存技術開発 ―精子を凍らせて保存する―
イタセンパラの精子を凍らせて保存できれば,イタセンパラの体の設計図とも言うべき遺伝子を保存できることになります。万が一,絶滅した場合でも,将来設計図があれば復活させることが可能かもしれません。他にも,卵を受精させるときに,いつでも精子が利用できれば,安定して計画的に増殖することが可能です。
そこで,氷の結晶が出来にくくする薬や凍らせる温度などを工夫し,イタセンパラの精子を液体窒素の中に凍結する方法を開発しました。
Ⅴ イタセンパラの野生復帰計画 ―絶滅の危機に瀕する淀川個体群を復活させる―
イタセンパラの生息できる環境が整った淀川の一部の水域へ、2009年秋に生物多様性センターで保存飼育していた親魚(雌雄各250個体、合計500個体)を放流しました.その結果、2010年の5~6月に稚魚133個体の生息を確認しました。→詳しくはこちら
アユモドキ
アユモドキは淀川水系と岡山県に分布しているドジョウの仲間の淡水魚です。岡山県や京都府では,今でも生息しているようですが,現在大阪府では,ほとんど見ることが出来ません。
生態
アユモドキは増水して水に浸かった河川敷にやってきて卵を産みます。水が退けばいつ干上がってしまうかもしれない不安定な環境ですが,卵は早ければ1日で孵化します。そして,すばやく成長し,氾濫が収まり再び河川敷が干上がってしまう前に川に戻ると言われています。増水しても早期に平常水位に戻る今の河川管理の現状では,産卵することが出来なかったり,産卵しても卵が干上がったりする可能性が高いと思われます。
寿命は4から5年で,15cm程になります。
人工授精からの繁殖
アユモドキを水槽や池の中で飼育しても,卵を産みません。そこで卵を産むために必要なホルモン剤を注射して,人工授精を行っています。春から夏にかけて,アユモドキのメスやオスにホルモン剤を注射し,卵や精液を採取しシャーレで受精させます。受精卵は卵割が起こり,1~2日でふ化します。ふ化した仔魚は成長するときれいな縞模様が現れます。
ニッポンバラタナゴ
以前,ニッポンバラタナゴは西日本に広く分布していたと考えられていますが,現在では,大阪府,香川県,福岡県の一部のみに生息しています。この魚は昔、中国、朝鮮半島から日本に分布していたバラタナゴの仲間が、日本列島に隔離され、そして日本の環境に合わせて独自に進化したという歴史をもっています。一方、大陸の環境に分化した魚は、タイリクバラタナゴといわれています。
ところが、外来魚であるタイリクバラタナゴが人為的に日本に移入し、両種が交ざりあってしまいました。すなわち、ニッポンバラタナゴのもっている独自の歴史が今、消えつつあります。
生物多様性センターでは,場内にニッポンバラタナゴ保存池を設け,累代保存すると共に,府内の分布を調査しています。